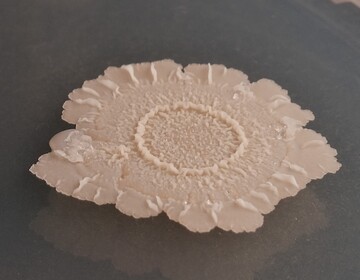
ie Mikrobe des Jahres 2023, Bacillus subtilis, bildet Biofilme mit vielfältigen Strukturen.

Als Leih-Oma ins Ausland
Was haben Kängurus, der Sänger Elton John und ein Koala gemeinsam? Sie bereiteten Leih-Oma Brigitte Ritz während ihres Aufenthalts in Australien viel Freude. Im Februar 2020 reiste sie als Granny Au-pair in den sechstgrößten Staat der Erde. Hier erzählt die 75-Jährige von ihren Abenteuern Down...